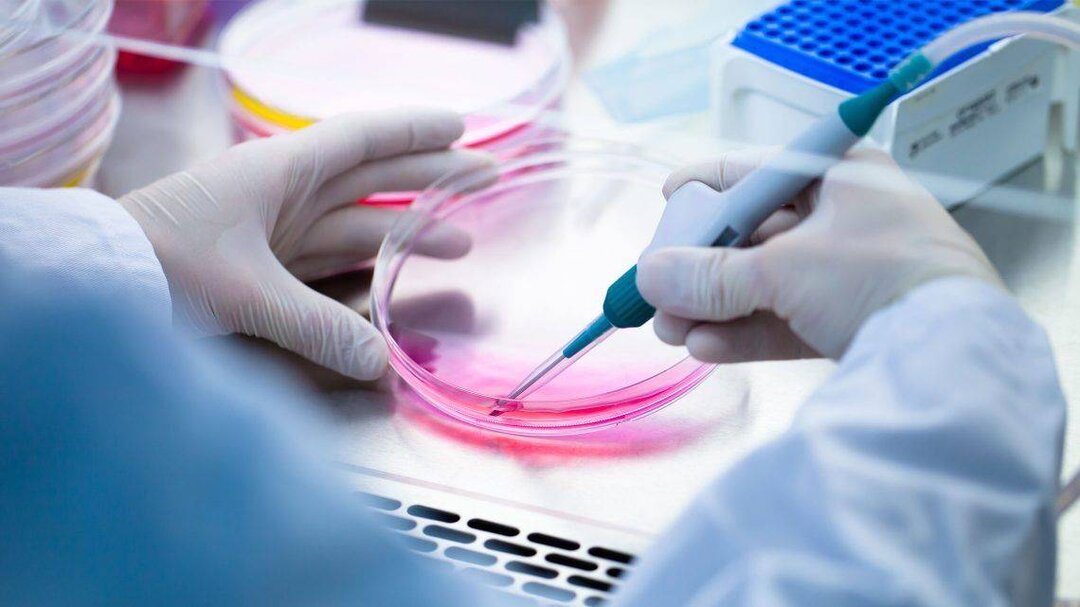
از عفو بیش از ۲۸۰۰ محکوم تا محکوم کردن فعالیتهای شرورانه رژیم اسرائیل توسط ایران

به گزارش خبرگزاری ایمنا، امروز در بسته خبری پنجره امید به سراغ عفو ۲۸۸۷ محکوم به مناسبت ولادت رسول اکرم (ص) و امام جعفر صادق (ع) میرویم، در ادامه نیز تلاش محققان ایرانی برای درمان سوختگی عمیق با سلول زنده مطرح شده است، همچنین حمایت از مقامآوران جشنواره موسیقی جوان و محکوم کردن فعالیتهای شرورانه رژیم اسرائیل توسط ایران در نشست شورای امنیت نیز از جمله موضوعاتی است که در ادامه جزئیات بیشتر آن بیان شده است.

جزئیات عفو مقام معظم رهبری به مناسبت ولادت رسول اکرم (ص) و امام جعفر صادق (ع)
حجتالاسلام صادق رحیمی، معاون قضائی قوه قضائیه درباره جزئیات عفو و تخفیف مجازات محکومان دادگاههای عمومی و انقلاب، سازمان قضائی نیروهای مسلح و سازمان تعزیرات حکومتی از سوی مقام معظم رهبری که به مناسبت ولادت رسول اکرم (ص) و حضرت امام جعفر صادق (ع) انجام شد، اظهار کرد: در این مرحله اسامی دو هزار و ۸۸۷ نفر که شرایط استحقاق عفو و تخفیف مجازات را داشتند و پرونده آنها در کمیسیون عفو و بخشودگی بررسی شده بود با تأیید ریاست قوه قضائیه به محضر مقام معظم رهبری اعلام و در نهایت عفو آنها مورد موافقت ایشان قرار گرفت.
وی افزود: از مجموع دو هزار و ۸۸۷ نفر مشمول عفو و تخفیف مجازات در این مرحله دو هزار و ۷۴۵ نفر از محکومان محاکم عمومی و انقلاب، ۱۱ نفر از محکومان سازمان قضائی نیروهای مسلح و ۱۳۱ نفر مربوط به محکومان سازمان تعزیرات حکومتی است.
معاون قضائی قوه قضائیه اضافه کرد: از دو هزار و ۷۴۵ نفر محکومان محاکم عمومی و انقلاب که مشمول عفو و تخفیف مجازات شدهاند، هزار و ۲۹۱ نفر مشمول عفو منتهی به آزادی و مختومه شدن پرونده و هزار و ۵۹۶ نفر باقیمانده مشمول تخفیف مجازات شدند.
حجتالاسلام رحیمی درباره محکومان دادگستریها که مشمول عفو رهبری شدهاند، گفت: ۵۹ نفر از افرادی که در این دوره مشمول عفو شدهاند، مجازات قطعی آنها اعدام بود که با یک درجه تخفیف، مجازات آنها به حبس تغییر کرده است؛ هفت نفر از افراد نیز شرایط اولیه عفو در کمیسیون مرکزی عفو را نداشتند که با درخواست رئیس قوه قضائیه از مقام معظم رهبری و در اجرای ماده ۲۰ آئیننامه عفو و بخشودگی مشمول عفو شدند.
وی افزود: در این مرحله ۱۴۰ نفر از محکومان مشمول عفو از محکومان زن، ۴۰ نفر اتباع بیگانه، ۳۹ نفر محکومان امنیتی و شش نفر زیر ۱۸ سال هستند.
محققان ایرانی سوختگی عمیق را با سلول زنده درمان کردند
فناوران پژوهشگاه رویان موفق به ارائه روشی بر پایه سلول و بافت زنده برای درمان سوختگی شدهاند، این محققان با استفاده از یک قسمت پوست دورریز نوزاد این کار را انجام دادهاند.
انسیه حاجیزاده، مدیر مرکز توسعه فناوری محصولات پیشرفته رویان در توضیح روش فناورانه برای درمان سوختگی عمیق گفت: از یک نوزاد سالم با توجه به معاینات و تست خون سالم مادر و نوزاد، یک قطعه یک و نیم سانتیمتری از پوست دورریز را دریافت کرده و از آن میتوانیم برای هزاران بیمار بانکهای سلولی درست کرده و محصول تولید کنیم.
موفقیت محصول در مرحله نخست کارآزمایی بالینی
این محصول فناورانه در مرحله نخست کارآزمایی بالینی موفق بود و در این فاز، محصول برای پنج نفر از افرادی که دارای سوختگی عمیق بودند، استفاده شد. به گفته حاجیزاده بعد از استفاده در فاز اول کارآزمایی بالینی ثابت شد علاوه بر اینکه این روش خطری ندارد و به راحتی قابل استفاده است، باعث بهبود زخم سوختگی بدون عوارض جانبی نیز میشود.
به گفته مسئولان پژوهشگاه رویان این محصول در یک ماه گذشته تولید شده و هنوز تجاریسازی نشده است. مشابه این محصول در کره جنوبی تولید و وارد بازار شده و پیشبینی میشود این محصول ایرانی طی چند سال آینده تجاریسازی شود.

از مقامآوران جشنواره موسیقی جوان حمایت میکنیم
محمود سالاری، معاون امور هنری وزارت فرهنگ اظهار کرد: بسیار خوشحالم که به همت دوستانم در اداره کل موسیقی و انجمن موسیقی و باانگیزه و پشتکار استاد حمیدرضا اردلان جشنواره ملی موسیقی جوان به بهترین نحو در حال برگزاری است؛ در این دوره از هنرمندان ۳۰ استان کشور میزبانی میکنیم و این نشان میدهد که موسیقی ما در اقصینقاط کشور در بین نسل جوان هنرمند زنده و پویاست.
وی درباره حمایت از شرکتکنندگان حاضر در جشنواره موسیقی فجر افزود: وظیفه ما این است که در حد بضاعتمان از این عزیزان حمایت داشته باشیم و تلاش کنیم هر استان از میان هنرمندان خود، یک نفر را بهعنوان مفاخر خود در نظر بگیرد، تلاشمان این است که ابتدا با انجمن مفاخر و بنیاد ملی نخبگان و در مرحله بعد با دانشگاهها رایزنی کنیم.
معاون امور هنری وزارت فرهنگ با اشاره بهشرط آزمون عملی رشته هنر در دانشگاهها گفت: از آنجایی که ورود به رشته هنر همراه با آزمون عملی است، بسیاری در پشت درهای بسته دانشگاه میمانند، تلاشمان این است و با دانشگاهها رایزنیهایی داشتیم تا حداقل افرادی که حائز کسب مقام شدهاند، نتایج این داوری در آزمون عملی دانشگاه از آنها پذیرفته شود.

شورای امنیت به فعالیتهای شرورانه رژیم اسرائیل پایان دهد
امیر سعید ایروانی، سفیر و نماینده دائم ایران در سازمان ملل در نشست شورای امنیت درباره سوریه گفت: حملات تروریستی وحشیانهای که با هدف کشتار جمعی غیرنظامیان بیگناه در لبنان توسط رژیم اسرائیل در تاریخهای هفدهم و هجدهم سپتامبر و همچنین در بخشی از سوریه انجام شد، نقض آشکار حقوق بینالملل بهویژه حقوق بینالملل بشردوستانه و حقوق بشر است و جنایتی علیه بشریت به شمار میآید.
وی افزود: جمهوری اسلامی ایران به شدت این حملات تروریستی هولناک را محکوم میکند و از شورای امنیت میخواهد که رژیم اسرائیل را محکوم کند و اقدامات قاطعی برای پایان دادن به فعالیتهای شرورانه آن در منطقه انجام دهد.
ارشدترین دیپلمات جمهوری اسلامی ایران در سازمان ملل درباره سوریه نیز گفت: بهطور قاطع به یک راهحل سیاسی برای بحران سوریه پایبند هستیم، هرگونه راهحلی باید به حاکمیت و تمامیت ارضی سوریه احترام بگذارد، حضور غیرقانونی نیروهای خارجی، از جمله نیروهای ایالات متحده را پایان دهد، از بهرهبرداری ایالات متحده از منابع سوریه جلوگیری کند و همچنین حمایت مداوم رژیم اسرائیل و ایالات متحده از گروههای تروریستی را متوقف سازد.
ایروانی تصریح کرد: ایالات متحده و همپیمانانش همچنان به سیاست شکستخورده تحریمهای یکجانبه و غیرانسانی خود ادامه میدهند و از آنها به عنوان ابزاری برای مجازات جمعی مردم سوریه استفاده میکنند؛ همانطور که پیشتر نیز گفتهایم، این اقدامات زیانبار باید بهعنوان یک تعهد قانونی و ضرورت اخلاقی لغو شود، زیرا تنها موجب ایجاد سختیهای غیرضروری و مانع از بهبود سوریه میشوند.


نظر شما